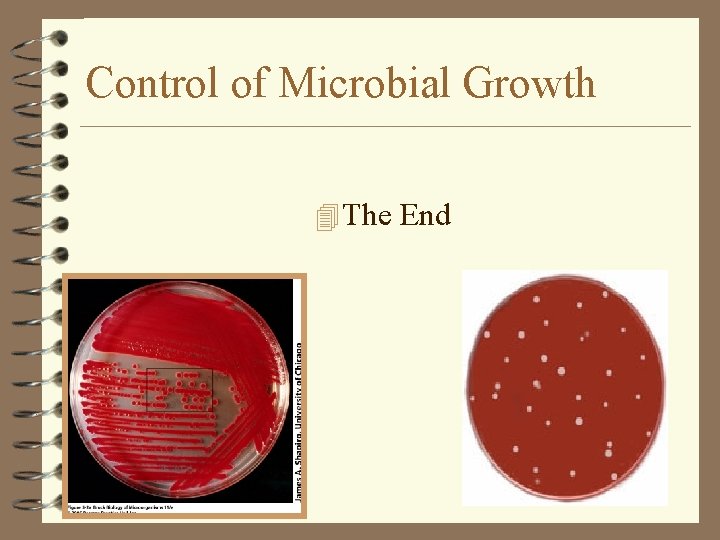
Control of Microbial Growth 4 The End

Control of Microbial Growth Yersinia pestis Gram bacillus

Control of Microbial Growth Yersinia pestis Gram (-) bacillus and cause Plague disease

Control of Microbial Growth: Introduction 4 Early civilizations practiced salting, smoking, drying, and exposure of food and clothing to sunlight to control microbial growth. 4 In mid 1800 s Lister helped developed aseptic techniques to prevent contamination of surgical wounds by using Carbolic acid (Phenol Compound). • Nosocomial infections caused death in 10% of surgeries. • Up to 25% mothers delivering in hospitals died due to infection

Control of Microbial Growth Terminology Sterilization: Killing or removing all forms of microbial life (including endospores) in a material or an object. Heating is the most commonly used method of sterilization. Commercial Sterilization: Heat treatment that kills endospores of Clostridium botulinum the causative agent of botulism, in canned food. Does not kill endospores of thermophiles, which are not pathogens and may grow at temperatures above 45 o. C.

Disinfection: Reducing the number of pathogenic microorganisms to the point where they no longer cause diseases. Usually involves the removal of vegetative or non-endospore forming pathogens. May use physical or chemical methods. u Disinfectant: Applied to inanimate objects. u Antiseptic: Applied to living tissue (antisepsis). u Degerming: Mechanical removal of most microbes in a limited area. Example: Alcohol swab on skin. u Sanitization: Use of chemical agent on food-handling equipment to meet public health standards and minimize chances of disease transmission. e. g: Hot soap & water.

Terminology Sepsis: Comes from Greek for decay or putrid. Indicates bacterial contamination. Asepsis: Absence of significant contamination. Aseptic techniques: are used to prevent contamination of surgical instruments, medical personnel, and the patient during surgery. Aseptic techniques are also used to prevent bacterial contamination in food industry.

Terminology Bacteriostatic Agent: An agent that inhibits the growth of bacteria, but does not necessarily kill them. Suffix stasis: To stop or steady. Germicide: An agent that kills certain M. O. u Bactericide: An agent that kills bacteria. Most do not kill endospores. u Fungicide: An agent that kills fungi. u Sporocide: An agent that kills bacterial endospores of fungal spores.


Control of Microbial Growth: Rate of Microbial Death Several factors influence the effectiveness of antimicrobial treatment. 1. Number of Microbes: The more microbes present, the more time it takes to eliminate population. 2. Type of Microbes: Endospores are very difficult to destroy. Vegetative pathogens vary widely in susceptibility to different methods of microbial control. 3. Environmental influences: Presence of organic material (blood, feces, saliva) tends to inhibit antimicrobials, p. H etc. 4. Time and Proper of Exposure: Chemical antimicrobials and radiation treatments are more effective at longer times. In heat treatments, longer exposure compensates for lower temperatures.

Actions of Microbial Control Agents 4 Alteration of plasma membrane – Loss of permeability barrier 4 Damage to proteins (enzymes) – Metabolism and transport disrupted 4 Damage to nucleic acids (DNA) – Cell cannot replicate or produce new enzymes 4 Cell Wall – Lysis

Methods to Control Microbial Growth 4 1. Physical 4 2. Chemical

1. Phsysical Methods of Microbial Control: Heat: Kills microorganisms by denaturing their enzymes and other proteins. Heat resistance varies widely among microbes. u. Thermal Death Point (TDP): Lowest temperature at which all of the microbes in a liquid suspension will be killed in ten minutes. u. Thermal Death Time (TDT): Minimal length of time in which all bacteria will be killed at a given temperature. u Decimal Reduction Time (DRT): Time in minutes at which 90% of bacteria at a given temperature will be killed. Used in canning industry.

Microbial death rates 4 Within any population of microbes, there are individuals that are either more or less susceptible to the anti-microbial agent used 4 Decimal reduction time used to define time it takes to kill 90% of organisms (heat)

Phsysical Methods of Microbial Control: Moist Heat: Kills microorganisms by coagulating their proteins. In general, moist heat is much more effective than dry heat. u Boiling: Heat to 100 o. C or more. Kills vegetative forms of bacterial pathogens, almost all viruses, and fungi and their spores within 10 minutes or less. Endospores and some viruses are not destroyed this quickly. However brief boiling will kill most pathogens. u Hepatitis virus: Can survive up to 30 minutes of boiling. u Endospores: Can survive up to 20 hours or more of boiling.

Phsysical Methods of Microbial Control: Moist Heat (Continued): Reliable sterilization with moist heat requires temperatures above that of boiling water. u Autoclave: Chamber which is filled with hot steam under pressure. Preferred method of sterilization, unless material is damaged by heat, moisture, or high pressure. u Temperature of steam reaches 121 o. C at twice atmospheric pressure. u Most effective when organisms contact steam directly or are contained in a small volume of liquid. u. All organisms and endospores are killed within 15 minutes. u Require more time to reach center of solid or large volumes of liquid.

Autoclave: Closed Chamber with High Temperature and Pressure

Table 7. 4

Kilit Ampule 4 Spores of Bacillus stearothermophilus ( Gram +ve rod, spore forming, thermophilic) 4 fermentable sugar 4 p. H indicator – basic - red – acid - yellow

Different indicators used to show if autoclave worked effectively tape Figure 7. 3

Phsysical Methods of Microbial Control: Moist Heat (Continued): u Pasteurization: Developed by Louis Pasteur to prevent the spoilage of beverages. Used to reduce microbes responsible for spoilage of beer, milk, wine, juices, etc. u Classic Method of Pasteurization: Milk was exposed to 65 o. C for 30 minutes. u High Temperature Short Time Pasteurization (HTST): Used today. Milk is exposed to 72 o. C for 15 seconds. u Ultra High Temperature Pasteurization (UHT): Milk is treated at 140 o. C for 3 seconds and then cooled very quickly in a vacuum chamber. Advantage: Milk can be stored at room temperature for several months.

Pasteurization 4 A High Temperature Is Used For a Short Time 4 Batch Method 63 °C for 30 Minutes 4 Flash Method 72 °C for 15 Seconds 4 Ultra-High-Temperature is 140 °C for 3 seconds

Other techniques using heat 4 Pasteurization doesn’t kill all microbes (is not sterilization). Coxiella and Listeria may survive. 4 Typically pasteurization only targets pathogens typically found in each food( Salmonella, Brucella, and Mycobacterium)

Phsysical Methods of Microbial Control: Dry Heat: Kills by oxidation effects. u Direct Flaming: Used to sterilize inoculating loops and needles. Heat metal until it has a red glow. u Incineration: Effective way to sterilize disposable items (paper cups, dressings) and biological waste. u Hot Air Sterilization (Oven) : Place objects in an oven. Require 2 hours at 160 o. C and 16 hours at 120 o. C for sterilization. Dry heat is transfers heat less effectively to a cool body, than moist heat.

Dry Heat Sterilization 4 Direct Flaming 4 Incineration 4 Hot-Air Sterilization (Oven)

Incineration • Burns and Physically Destroys Organisms • Used for a. Needles b. Inoculating Wires c. Glassware d. Body Parts?

Dry Heat (Hot Air Oven) • 160° C for 2 Hours or 180° C for 1 hour • Used for: a. Glassware b. Metal c. Objects That Won’t Melt Q: Is this method used to sterilize media with protein? And why?

Physical Methods of Microbial Control 4 Dry Heat Sterilization kills by oxidation – Flaming – Incineration – Hot-air sterilization Hot-air Equivalent treatments 180˚C, 2 hr Autoclave 121˚C, 15 min

Phsysical Methods of Microbial Control: Low Temperature: Effect depends on microbe and treatment applied. u Refrigeration: Temperatures from 0 to 7 o. C. Bacteriostatic effect. Reduces metabolic rate of most microbes so they cannot reproduce or produce toxins. u Freezing: Temperatures below 0 o. C. u. Flash Freezing: Does not kill most microbes. u. Slow Freezing: More harmful because ice crystals disrupt cell structure. u Over a third of vegetative bacteria may survive 1 year. u Most parasites are killed by a few days of freezing.

Other physical methods of microbial growth control 4 Refrigeration inhibits most microbial growth, but doesn’t kill pathogens (mostly mesophiles); Yersinia and Listeria not inhibited 4 Slow freezing kills only susceptible organisms, but many microbes survive frozen for years 4 Desiccation inhibits growth of bacteria, but not molds 4 Lyophilization (freeze-drying) is used to preserve microbes

Physical Methods of Microbial Control: Filtration: Removal of microbes by passage of a liquid or gas through a screen like material with small pores. Used to sterilize heat sensitive materials like vaccines, enzymes, antibiotics, and some culture media. u High Efficiency Particulate Air Filters (HEPA): Used in operating rooms and burn units to remove bacteria from air. u Membrane Filters: Uniform pore size. Used in industry and research. Different sizes: u 0. 22 and 0. 45μm Pores: Used to filter most bacteria. Don’t retain spirochetes, mycoplasmas and viruses. u 0. 01 μm Pores: Retain all viruses and some large proteins.


HEPA Filters 4 High-Efficiency Particulate Air Filters 1. Operating Rooms 2. Burn Units 3. Fume Hoods

Phsysical Methods of Microbial Control: Dessication: In the absence of water, microbes cannot grow or reproduce, but some may remain viable for years. After water becomes available, they start growing again. Susceptibility to dessication varies widely: u Neisseria gonnorrhea: Only survives about one hour. u Mycobacterium tuberculosis: May survive several months. u Viruses are fairly resistant to dessication. u Clostridium spp. and Bacillus sp. : May survive decades.

Phsysical Methods of Microbial Control: Osmotic Pressure: The use of high concentrations of salts and sugars in foods is used to increase the osmotic pressure and create a hypertonic environment. Plasmolysis: As water leaves the cell, plasma membrane shrinks away from cell wall. Cell may not die, but usually stops growing. u Yeasts and molds: More resistant to high osmotic pressures. u Staphylococci sp. that live on skin are fairly resistant to high osmotic pressure.

Phsysical Methods of Microbial Control: Radiation: Three types of radiation kill microbes: 1. Ionizing Radiation: Gamma rays, X rays, electron beams, or higher energy rays. Have short wavelengths (less than 1 nanometer). Dislodge electrons from atoms and form ions. Cause mutations in DNA and produce peroxides. Used to sterilize pharmaceuticals and disposable medical supplies. Food industry is interested in using ionizing radiation. Disadvantages: Penetrates human tissues. May cause genetic mutations in humans.

Forms of Radiation

Phsysical Methods of Microbial Control: Radiation: Three types of radiation kill microbes: 2. Ultraviolet light (Nonionizing Radiation): Wavelength is longer than 1 nanometer. Damages DNA by producing thymine dimers, which cause mutations. Used to disinfect operating rooms, nurseries, cafeterias. Disadvantages: Damages skin, eyes. Doesn’t penetrate paper, glass, and cloth.

Radiation 4 Electromagnetic radiation includes (in decreasing order of wavelength=energy) electron beams, gamma-rays, x-rays, UV light, visible light and infrared light. 4 All radiation with wavelength < 1 nm are ionizing = have sufficient energy to knock electrons off an atom 4 Most non-ionizing radiation is not sufficiently energetic to kill microbe, except UV light, which injures DNA, but does not penetrate well 4 Microwaves kill by secondary heat effect

Radiation 4 Ionizing Radiation 1. High Degree of Penetration 2. Examples - Gamma Rays - X-rays - High Energy Electron Beams 4 Ultraviolet Radiation 1. Nonionizing 2. Low Degree of Penetration 3. Low Penetration 4. Harmful / Skin / Eyes 5. Cell Damage / Thymine 6. Germicidal / 260 nm

Phsysical Methods of Microbial Control: Radiation: Three types of radiation kill microbes: 3. Microwave Radiation: Wavelength ranges from 1 millimeter to 1 meter. Heat is absorbed by water molecules ( ionized water). May kill vegetative cells in moist foods. Bacterial endospores, which do not contain water, are not damaged by microwave radiation. Solid foods are unevenly penetrated by microwaves.

Microwaves 4 Kill Microbes Indirectly with Heat

2. Chemical Methods to Control Microbial Growth

Chemical Methods of Microbial Control Types of Disinfectants 1. Phenols and Phenolics: u Phenol (carbolic acid) was first used by Lister as a disinfectant. u u Phenolics are chemical derivatives of phenol u u Rarely used today because it is a skin irritant and has strong odor. Used in some throat sprays. Acts as local anesthetic. Cresols: Derived from coal tar (Lysol). Biphenols (p. Hiso. Hex): Effective against gram-positive staphylococci and streptococci. Used in nurseries. Excessive use in infants may cause neurological damage. Destroy plasma membranes and denature proteins. Advantages: Stable, persist for long times after applied, and remain active in the presence of organic compounds.

Types of Disinfectants 4 Phenolics. Lysol 4 Bisphenols. Hexachlorophene Triclosan Figure 7. 7

Types of Disinfectants 4 Phenol and Phenolics - Another Name for Carbolic Acid / Lysol - Joseph Lister - Exert Influence By 1. Injuring Plasma membranes 2. Inactivating Enzymes 3. Denaturing Proteins - Long Lasting, Good for Blood and Body Fluids, No Effect on Spores

Evaluating a Disinfectant 4 Old Standard is the Phenol Coefficient Test (FYI -- The phenol coefficient is the value obtained by dividing the highest dilution of the test solution by the highest dilution of phenol that sterilizes the given culture of bacteria under standard conditions of time and temperature. )

Chemical Methods of Microbial Control Types of Disinfectants 2. Halogens: Effective alone or in compounds. A. Iodine: u Tincture of iodine (alcohol solution) was one of first antiseptics used. u Combines with amino acid tyrosine in proteins and denatures proteins. u Stains skin and clothes, somewhat irritating. u Iodophors: Compounds with iodine that are slow releasing, take several minutes to act. Used as skin antiseptic in surgery. Not effective against bacterial endospores.

Chemical Methods of Microbial Control Types of Disinfectants 2. Halogens: Effective alone or in compounds. B. Chlorine: u When mixed in water forms hypochlorous acid: Cl 2 + H 2 O ------> H+ + Cl- + HOCl Hypochlorous acid u u Used to disinfect drinking water, pools, and sewage. Chlorine is easily inactivated by organic materials. Sodium hypochlorite (Na. OCl): Is active ingredient of bleach. Chloramines: Consist of chlorine and ammonia. Less effective as germicides.

Chemical Methods of Control Types of Disinfectants 3. Alcohols: u u u Kill bacteria, fungi, but not endospores or naked viruses. Act by denaturing proteins and disrupting cell membranes. Evaporate, leaving no residue. Used to mechanically wipe microbes off skin before injections or blood drawing. Not good for open wounds, because proteins to coagulate. u u Ethanol: Drinking alcohol. Optimum concentration is 70%. Isopropanol: Rubbing alcohol. Better disinfectant than ethanol. Also cheaper and less volatile.

Types of Disinfectants 4 Alcohols. Ethanol, isopropanol – Denature proteins, dissolve lipids Table 7. 6

Chemical Methods of Control Types of Disinfectants 4. Heavy Metals: Include copper, selenium, mercury, silver, and zinc. u Oligodynamic action: Very tiny amounts are effective. Denature proteins. A. Silver: u 1% silver nitrate used to protect infants against gonorrheal eye infections until recently. B. Mercury u Organic mercury compounds like mercurochrome are used to disinfect skin wounds. C. Copper u Copper sulfate is used to kill algae in pools and fish tanks. u

Chemical Methods of Control Types of Disinfectants 4. Heavy Metals: D. Selenium u Kills fungi and their spores. Used for fungal infections. u Also used in shampoos. E. Zinc u Zinc chloride is used in mouthwashes. u Zinc oxide is used as antifungal agent in paints.

Chemical Methods of Control Types of Disinfectants 5. Quaternary Ammonium Compounds (QAC): u Widely used surface active agents. u u u u Cationic (positively charge) detergents. Effective against gram positive bacteria, less effective against gram-negative bacteria. Also destroy fungi, amoebas, and enveloped viruses. Zephiran, Cepacol, also found in our lab spray bottles. Pseudomonas strains that are resistant and can grow in presence of QAC are a big concern in hospitals. Advantages: Strong antimicrobial action, colorless, odorless, tasteless, stable, and nontoxic. Diasadvantages: Form foam. Organic matter interferes with effectiveness. Neutralized by soaps and anionic detergents.

Types of Disinfectants 4 Surface-Active Agents or Surfactants Soap Degerming Acid-anionic detergents Quarternary ammonium compounds Cationic detergents Sanitizing Bactericidal, Denature proteins, disrupt plasma membrane

Types of Disinfectants 4 Chemical Food Preservatives – Organic Acids • Inhibit metabolism • Sorbic acid, benzoic acid, calcium propionate • Control molds and bacteria in foods and cosmetics – Nitrite prevents endospore germination – Antibiotics. natamycin prevent spoilage of cheese

Types of Disinfectants 4 Chemical Food Preservatives - Sorbic Acid Benzoic Acid Inhibit Fungus Propionic Acid Nitrate and Nitrite Salts / Meats / To Prevent Germination of Clostridium botulinum endospores

Chemical Methods of Control Types of Disinfectants 6. Aldehydes: u Include some of the most effective antimicrobials. u u u Inactivate proteins by forming covalent crosslinks with several functional groups. A. Formaldehyde gas: Excellent disinfectant. Commonly used as formalin, a 37% aqueous solution. Formalin was used extensively to preserve biological specimens and inactivate viruses and bacteria in vaccines. Irritates mucous membranes, strong odor. Also used in mortuaries for embalming.

Chemical Methods of Control Types of Disinfectants 6. Aldehydes: B. Glutaraldehyde: u Less irritating and more effective than formaldehyde. u One of the few chemical disinfectants that is a sterilizing agent. u A 2% solution of glutaraldehyde (Cidex) is: u u Bactericidal, tuberculocidal, and viricidal in 10 minutes. Sporicidal in 3 to 10 hours. Commonly used to disinfect hospital instruments. Also used in mortuaries for embalming.

Chemical Methods of Control Types of Disinfectants 7. Gaseous Sterilizers: Chemicals that sterilize in a chamber similar to an autoclave. u Denature proteins, by replacing functional groups with alkyl groups. A. Ethylene Oxide: u Kills all microbes and endospores, but requires exposure of 4 to 18 hours. u Toxic and explosive in pure form. u Highly penetrating. u Most hospitals have ethylene oxide chambers to sterilize mattresses and large equipment. u

Chemical Methods of Control Types of Disinfectants 8. Peroxygens (Oxidizing Agents): Oxidize cellular components of treated microbes. u Disrupt membranes and proteins. A. Ozone: u Used along with chlorine to disinfect water. u Helps neutralize unpleasant tastes and odors. u More effective killing agent than chlorine, but less stable and more expensive. u Highly reactive form of oxygen. u Made by exposing oxygen to electricity or UV light. u

Chemical Methods of Control Types of Disinfectants B. Hydrogen Peroxide: u Used as an antiseptic. u Not good for open wounds because quickly broken down by catalase present in human cells. u Effective in disinfection of inanimate objects. u Sporicidal at higher temperatures. u Used by food industry and to disinfect contact lenses.

Chemical Methods of Control Types of Disinfectants C. Peracetic Acid: u One of the most effective liquid sporicides available. u Sterilant : u u u Kills bacteria and fungi in less than 5 minutes. Kills endospores and viruses within 30 minutes. Used widely in disinfection of food and medical instruments because it does not leave toxic residues.

Microbial Characteristics and Microbial Control Figure 7. 11

Microbial Characteristics and Microbial Control Chemical agent Phenolics QAC Chlorines Alcohols Glutaraldehyde Effectiveness against Endospores Mycobacteria Poor Good None Fair Poor Good Fair Good



Efficiency of Different Chemical Antimicrobial Agents

Chemical disinfectants 4 Spores and cysts not very susceptible to chemicals 4 Phenols (Lysol, triclosan) interrupt membranes and denature proteins and are low-to-mid level disinfectants 4 Alcohols dissolve membranes and denature proteins, are considered mid-level disinfectants 4 Halogens are reactive compounds that will kill some spores 4 Oxidizing agents (peroxides, ozone) kill by oxidizing enzymes
Control of Microbial Growth 4 The End
- Slides: 68